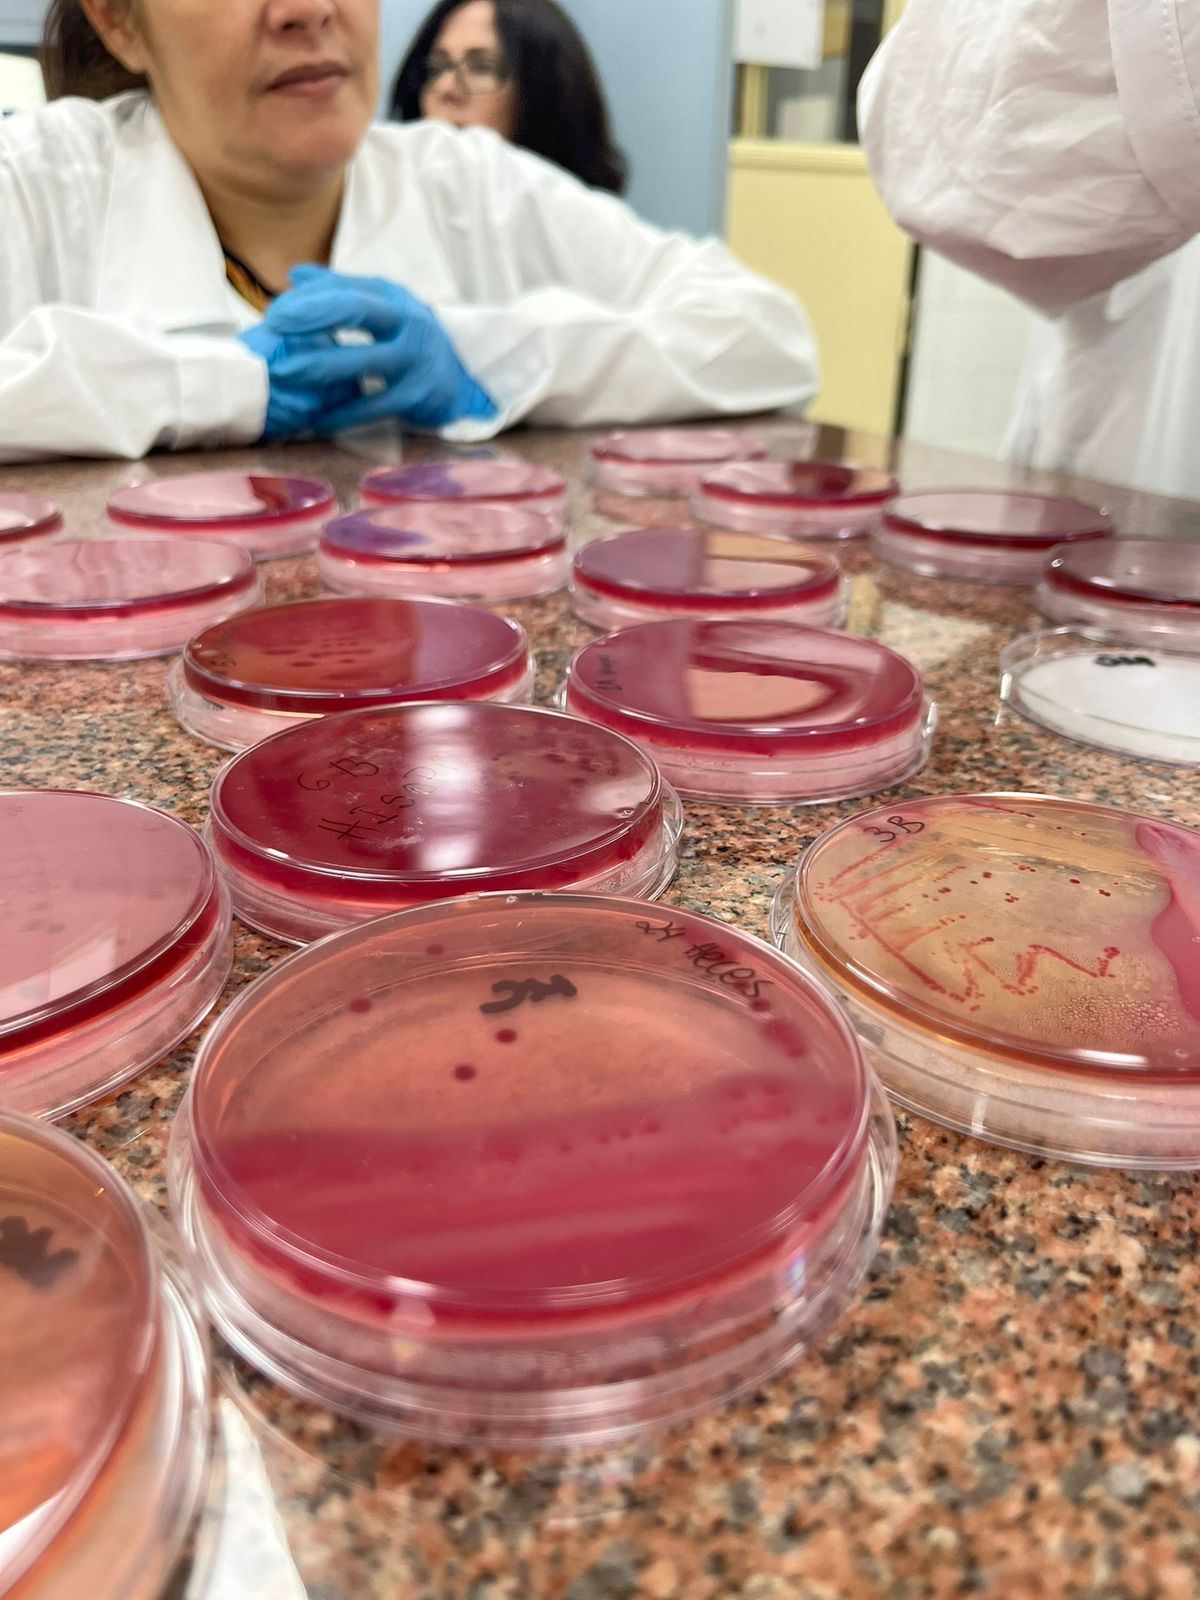
""técnico de PANAFTOSA capacitando personal de laboratorio de Paraguay en inocuidad de alimentos y RAM

Paraguay
Asunción, Paraguay, 18 diciembre de 2025 (PANAFTOSA/SPV-OPS/OMS) - En el marco del Proyecto “Fortalecimiento de las funciones críticas de prevención, preparación y respuesta ante pandemias en Paraguay”, el país fortaleció sus capacidades de laboratorio a través de una capacitación teórico-práctica orientada a fortalecer la detección y caracterización de patógenos transmitidos por alimentos y sus variantes resistentes a los antimicrobianos (RAM).
El proyecto tiene como entidades implementadoras la Organización Panamericana de la Salud (OPS), la Organización de las Naciones Unidas para la Alimentación y Agricultura (FAO), el Fondo de las Naciones Unidas para la Infancia (UNICEF) y el Banco Interamericano de Desarrollo (BID).
La actividad fue organizada por el Servicio Nacional de Calidad y Salud Animal (SENACSA), con la participación técnica del Centro Panamericano de Fiebre Aftosa y Salud Pública Veterinaria (PANAFTOSA-OPS) y apoyo de la FAO.
La RAM es una amenaza creciente para la salud pública y la inocuidad alimentaria. En este contexto, el proyecto promueve la vigilancia integrada bajo el enfoque de Una Sola Salud, articulando los sectores de salud humana, animal y ambiental.
Durante cinco días de capacitación, técnicos del SENACSA, del Servicio Nacional de Calidad y Sanidad Vegetal y de Semillas (SENAVE) y del Ministerio del Ambiente y Desarrollo Sostenible (MADES) fortalecieron sus competencias en aislamiento e identificación de patógenos, pruebas fenotípicas de resistencia a los antimicrobianos, técnicas moleculares, análisis de genes de RAM y bioinformática. También se abordaron métodos de validación, mecanismos emergentes de resistencia y criterios internacionales para su interpretación.
La actividad contribuyó a reforzar el sistema nacional de vigilancia de la RAM, promoviendo la armonización de métodos y la colaboración interinstitucional, aspectos clave para avanzar hacia una respuesta integrada y sostenible frente a esta amenaza sanitaria.